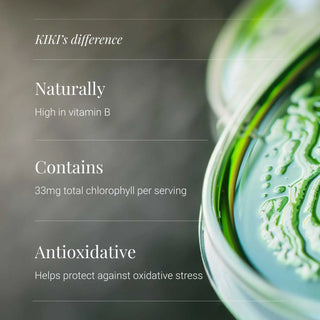
Spirulina Tablets, Organic - 200 Tablets KIKI Health

Key
benefits
KIKI's guarantee

Want to know more?
We use a unique tableting method to ensure that no binders or fillers are used, which means that unlike most other spirulina tablets on the market, our spirulina tablets contain simply 100% pure organic spirulina.
It is grown in man made ‘spirulina raceway ponds’. These are monitored to ensure a neutral/balanced production, and third party tested with each batch to ensure no heavy metals and other nasties are present.
Spirulina is type of blue-green freshwater algae that grows naturally in tropical and sub-tropical lakes.
25+ years of expertise
Wholefood ingredients
Ingredients in their natural form — nothing isolated, nothing synthetic.
100% active
No fillers. No bulking agents. Just what your body recognises.
Ethically sourced
Chosen for purity, provenance and environmental integrity.
Expert-led formulations
Science-led, evidence-based, refined over decades.
Nutrient-dense
Concentrated nutrition, delivered in effective amounts.
Targeted support
Formulas created to support the body as a whole.